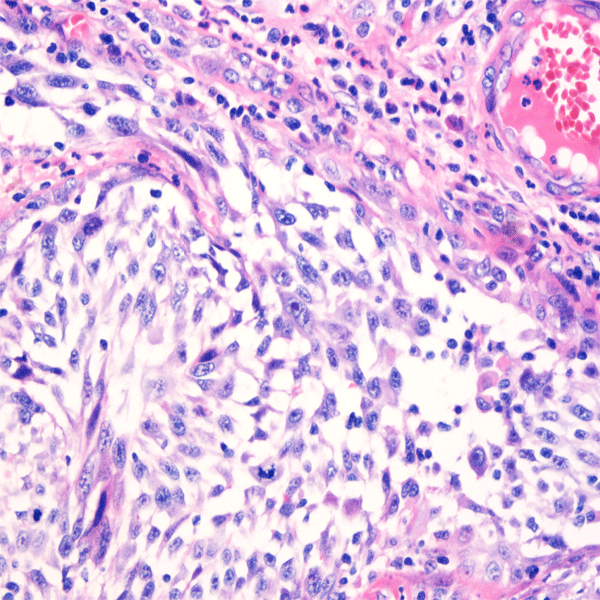

PRODUCT CATEGORY
PRODUCT CATEGORY
CONTACT US
Phone
Email
Address
6 Cuizhu St, Zhong Yuan Qu, Zheng Zhou Shi, He Nan Sheng, China, 450001
Eosin Staining Solution
Eosin is an acid stain which mainly makes the components in the cytoplasm and extracellular matrix stain red. Celnovte Bio-tech has self-developed Eosin staining product which has stronger coloring ability, shorter staining time, brighter colors, and constant color for a long time.
Product Features
- Product Functions: For Cytoplasmic Staining
- Storage: 15-30℃
- Components: Eosin Y Disodium, Ethanol A
- Shelf Life: 12 months;The unsealed reagent is 3 months
- Registration of Certificates: HZXB20170058
More Info
Staining Results: